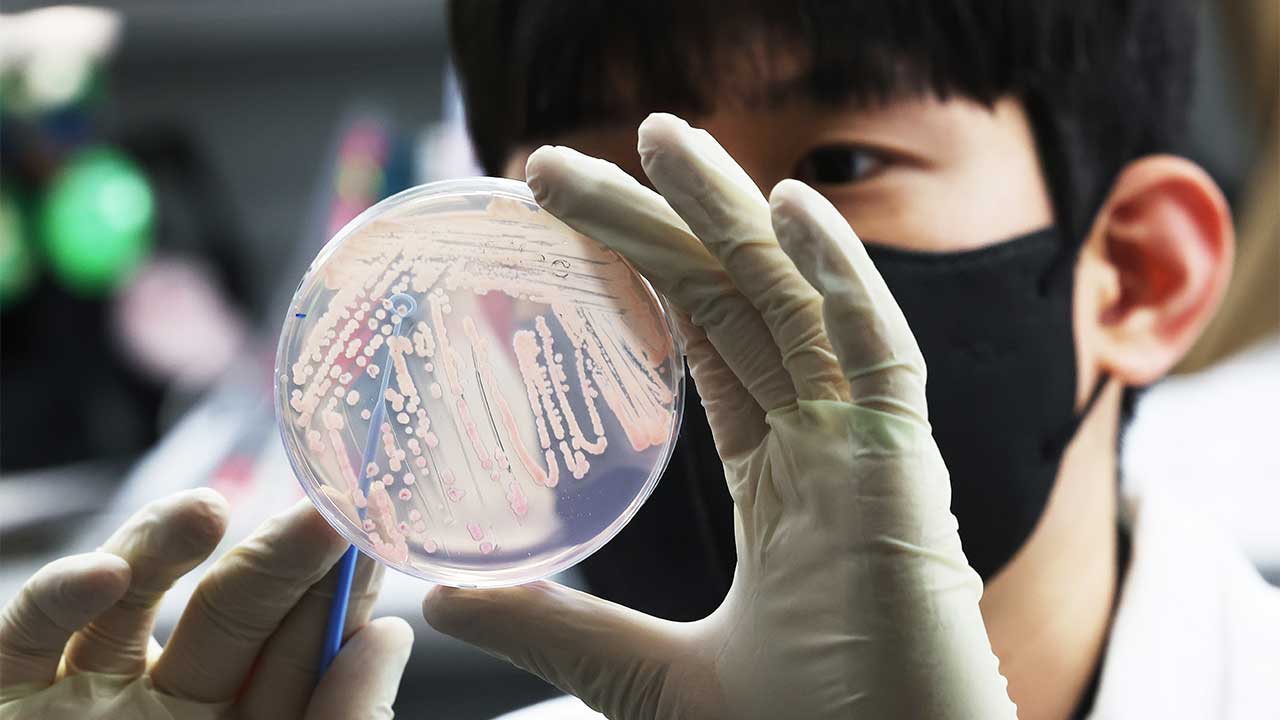
경북 영양서 라면에 산나물 넣어 먹은 주민 6명 식중독 증세

※ 사진은 기사 내용과 직접적인 관련이 없습니다 [자료사진]
소방당국에 따르면 이들은 구토와 마비 등의 증상을 호소했으며, 6명 가운데 4명은 증세가 심하고 나머지 2명은 비교적 가벼운 상태로 알려졌습니다.
보건당국은 가검물 등을 수거해 역학 조사를 진행하고 있습니다.
 손하늘
손하늘
※ 사진은 기사 내용과 직접적인 관련이 없습니다 [자료사진]
당신의 의견을 남겨주세요